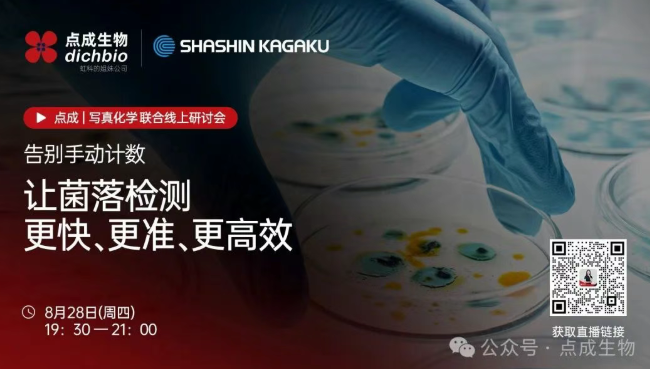
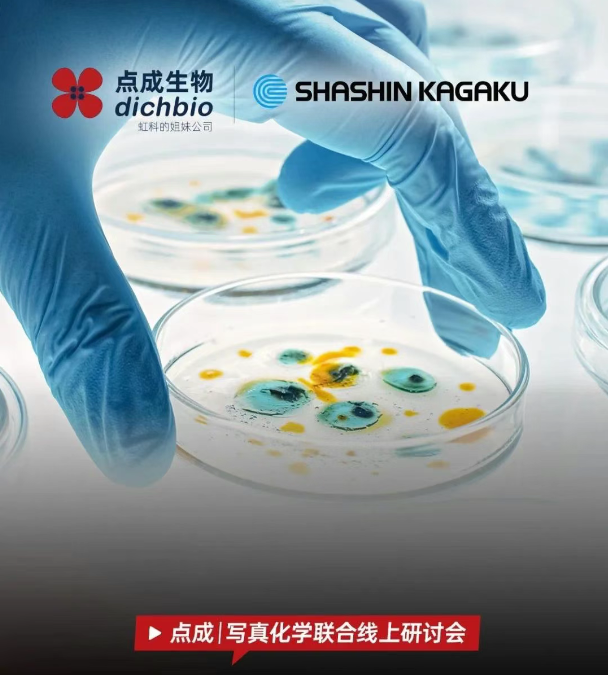

是誰(shuí)在偷偷拖慢你的實(shí)驗(yàn)室進(jìn)度?

你的微生物檢測(cè)還在靠“眼力”和“手動(dòng)”嗎?面對(duì)2025新藥典的嚴(yán)格要求和不斷增加的檢測(cè)樣本,傳統(tǒng)計(jì)數(shù)不僅費(fèi)時(shí)費(fèi)力,還可能因?yàn)槠诙鴮?dǎo)致數(shù)據(jù)不準(zhǔn)。
8月28日晚19:30,我們將舉辦一場(chǎng)微生物檢測(cè)效率的直播,我們將為您展示,如何通過(guò)更精準(zhǔn)、更高效的方式,讓您的微生物檢測(cè)工作實(shí)現(xiàn)質(zhì)的飛躍。
這場(chǎng)直播適合誰(shuí)看?
如果你是制藥QC/QA、第三方檢測(cè)機(jī)構(gòu)、食品廠品控或科研人員,你一定深有體會(huì):
🔹 重復(fù)繁瑣: 每天面對(duì)成百上千個(gè)培養(yǎng)皿,數(shù)到眼花,數(shù)到手抖
🔹 結(jié)果不一: 同樣的樣本,不同的人數(shù),結(jié)果大相徑庭,重復(fù)測(cè)試耗費(fèi)巨大
🔹 合規(guī)挑戰(zhàn): 審計(jì)時(shí)要求提供歷史圖像和數(shù)據(jù),手動(dòng)記錄的風(fēng)險(xiǎn)有多高?
🔹 樣本復(fù)雜: 遇到重疊菌落、霉菌、或背景復(fù)雜、顏色相近的樣本,人工計(jì)數(shù)幾乎成了“玄學(xué)”
——如果以上任何一點(diǎn)戳中了你,那么這場(chǎng)直播就是為你量身打造!